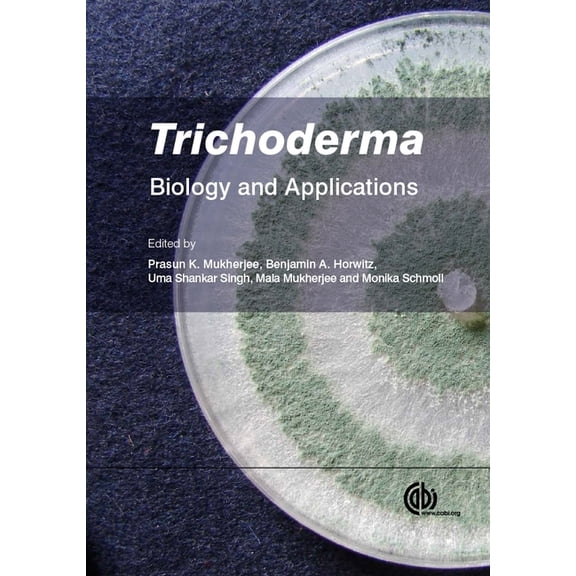
Trichoderma: Biology and Applications, (Hardcover)

Trichoderma(37)
Uses item details. Price when purchased online
Trichoderma (Paperback) $42.53

$4253
current price $42.53Trichoderma (Paperback)
Sghaier-C: Trichoderma, Book 1 (Paperback Edition) $44.46

$4446
current price $44.46Sghaier-C: Trichoderma, Book 1 (Paperback Edition)
Trichoderma: Biology and Applications, (Hardcover) $231.01
$23101
current price $231.01Trichoderma: Biology and Applications, (Hardcover)
Trichoderma: un potenziale agente di biocontrollo, (Paperback) $64.00

$6400
current price $64.00Trichoderma: un potenziale agente di biocontrollo, (Paperback)
Save with
Trichoderma: um potencial agente de controlo biolgico, (Paperback) $64.00

$6400
current price $64.00Trichoderma: um potencial agente de controlo biolgico, (Paperback)
Save with
Trichoderma: potencjalny rodek biologiczny, (Paperback) $64.00

$6400
current price $64.00Trichoderma: potencjalny rodek biologiczny, (Paperback)
Save with
Soil Biology Trichoderma: Agricultural Applications and Beyond, Book 61, (Paperback) $248.80

$24880
current price $248.80Soil Biology Trichoderma: Agricultural Applications and Beyond, Book 61, (Paperback)
Save with
Trichoderma: Ganoderma Disease Control in Oil Palm: A Manual, (Paperback) $34.52

$3452
current price $34.52Trichoderma: Ganoderma Disease Control in Oil Palm: A Manual, (Paperback)
Save with
Trichoderma: Ein potenzieller biologischer Bekmpfungsstoff, (Paperback) $64.00

$6400
current price $64.00Trichoderma: Ein potenzieller biologischer Bekmpfungsstoff, (Paperback)
Save with
Rhizosphere Biology Trichoderma: Host Pathogen Interactions and Applications, (Paperback) $169.99

$16999
current price $169.99Rhizosphere Biology Trichoderma: Host Pathogen Interactions and Applications, (Paperback)
Save with
Pre-Owned Trichoderma: Biology and Applications (Hardcover 9781780642475) by Lea Atanasova, Prasun K Mukherjee, Bryan A Bailey $65.01

$6501
current price $65.01Pre-Owned Trichoderma: Biology and Applications (Hardcover 9781780642475) by Lea Atanasova, Prasun K Mukherjee, Bryan A Bailey
Trichoderma Biological Control Agent: Phylogeny to Formulation, (Paperback) $150.00

$15000
current price $150.00Trichoderma Biological Control Agent: Phylogeny to Formulation, (Paperback)
Save with
Trichoderma Sp. and Biological Control of Soil Fungi, (Paperback) $57.00

$5700
current price $57.00Trichoderma Sp. and Biological Control of Soil Fungi, (Paperback)
Save with
Soil Biology Trichoderma: Agricultural Applications and Beyond, Book 61, (Hardcover) $266.55

$26655
current price $266.55Soil Biology Trichoderma: Agricultural Applications and Beyond, Book 61, (Hardcover)
Rhizosphere Biology Trichoderma: Host Pathogen Interactions and Applications, (Hardcover) $141.46

$14146
current price $141.46Rhizosphere Biology Trichoderma: Host Pathogen Interactions and Applications, (Hardcover)
Save with
Trichoderma Sp. E Controlo Biolgico de Fungos Do Solo, (Paperback) $57.00

$5700
current price $57.00Trichoderma Sp. E Controlo Biolgico de Fungos Do Solo, (Paperback)
Save with
Pre-Owned Biotechnology and Biology of Trichoderma, (Hardcover) $258.80

$25880
current price $258.80Pre-Owned Biotechnology and Biology of Trichoderma, (Hardcover)
Trichoderma Sp. Und Die Biologische Bekmpfung Von Bodenpilzen, (Paperback) $57.00

$5700
current price $57.00Trichoderma Sp. Und Die Biologische Bekmpfung Von Bodenpilzen, (Paperback)
Save with
Genetic diversity analysis of Trichoderma isolates, (Paperback) $68.68

$6868
current price $68.68Genetic diversity analysis of Trichoderma isolates, (Paperback)
Save with
Biotechnology and Biology of Trichoderma, (Hardcover) $249.75

$24975
current price $249.75Biotechnology and Biology of Trichoderma, (Hardcover)
Trichoderma Sp. Y Control Biolgico de Hongos del Suelo, (Paperback) $51.00

$5100
current price $51.00Trichoderma Sp. Y Control Biolgico de Hongos del Suelo, (Paperback)
Save with
PATHOGENICITY AND BIOLOGICAL CONTROL OF Fusarium WITH Trichoderma, (Paperback) $59.00

$5900
current price $59.00PATHOGENICITY AND BIOLOGICAL CONTROL OF Fusarium WITH Trichoderma, (Paperback)
Save with
Fungal Biology Advances in Trichoderma Biology for Agricultural Applications, (Hardcover) $155.93

$15593
current price $155.93Fungal Biology Advances in Trichoderma Biology for Agricultural Applications, (Hardcover)
Save with
New and Future Developments in Microbial Biotechnology and Bioengineering: Trichoderma for Biotechnological Applications, (Paperback) $210.00

$21000
current price $210.00New and Future Developments in Microbial Biotechnology and Bioengineering: Trichoderma for Biotechnological Applications, (Paperback)
Save with
Methods in Molecular Biology Trichoderma Reesei: Methods and Protocols, Book 2234, (Paperback) $113.16

$11316
current price $113.16Methods in Molecular Biology Trichoderma Reesei: Methods and Protocols, Book 2234, (Paperback)
Save with
Trichoderma Sp. Et Lutte Biologique Contre Les Champignons Du Sol, (Paperback) $57.00

$5700
current price $57.00Trichoderma Sp. Et Lutte Biologique Contre Les Champignons Du Sol, (Paperback)
Save with
Fungal Biology Practical Handbook of the Biology and Molecular Diversity of Trichoderma Species from Tropical Regions, (Hardcover) $107.90

$10790
current price $107.90Fungal Biology Practical Handbook of the Biology and Molecular Diversity of Trichoderma Species from Tropical Regions, (Hardcover)
Fungal Biology Advances in Trichoderma Biology for Agricultural Applications, (Paperback) $155.92

$15592
current price $155.92Fungal Biology Advances in Trichoderma Biology for Agricultural Applications, (Paperback)
Save with
Methods in Molecular Biology Trichoderma Reesei: Methods and Protocols, Book 2234, (Hardcover) $163.87

$16387
current price $163.87Methods in Molecular Biology Trichoderma Reesei: Methods and Protocols, Book 2234, (Hardcover)
PATHOGENITT UND BIOLOGISCHE BEKMPFUNG VON Fusarium mit Trichoderma, (Paperback) $58.66

$5866
current price $58.66PATHOGENITT UND BIOLOGISCHE BEKMPFUNG VON Fusarium mit Trichoderma, (Paperback)
Save with
Vertrglichkeit und Empfindlichkeit von Trichoderma viride gegenber Pestiziden, (Paperback) $54.00

$5400
current price $54.00Vertrglichkeit und Empfindlichkeit von Trichoderma viride gegenber Pestiziden, (Paperback)
Save with
Analyse der genetischen Vielfalt von Trichoderma-Isolaten, (Paperback) $64.00

$6400
current price $64.00Analyse der genetischen Vielfalt von Trichoderma-Isolaten, (Paperback)
Save with
Anlise da diversidade gentica de isolados de Trichoderma, (Paperback) $62.31

$6231
current price $62.31Anlise da diversidade gentica de isolados de Trichoderma, (Paperback)
Analyse de la diversit gntique des isolats de Trichoderma, (Paperback) $64.00

$6400
current price $64.00Analyse de la diversit gntique des isolats de Trichoderma, (Paperback)
Save with
Bioactive Compounds from Marine-Derived Aspergillus, Penicillium, Talaromyces and Trichoderma Species, (Paperback) $43.61

$4361
current price $43.61Bioactive Compounds from Marine-Derived Aspergillus, Penicillium, Talaromyces and Trichoderma Species, (Paperback)
Save with
Compatibilidade e sensibilidade de Trichoderma viride contra pesticidas, (Paperback) $54.00

$5400
current price $54.00Compatibilidade e sensibilidade de Trichoderma viride contra pesticidas, (Paperback)
Save with
New and Future Developments in Microbial Biotechnology and Bioengineering: Recent Developments in Trichoderma Research, (Paperback) $273.73

$27373
current price $273.73New and Future Developments in Microbial Biotechnology and Bioengineering: Recent Developments in Trichoderma Research, (Paperback)
Other options to consider(7)
Beneficial Microorganisms in Multicellular Life Forms, (Paperback) $182.67

$18267
current price $182.67Beneficial Microorganisms in Multicellular Life Forms, (Paperback)
Trichoderma Sp. E Controllo Biologico Dei Funghi del Suolo, (Paperback) $57.00

$5700
current price $57.00Trichoderma Sp. E Controllo Biologico Dei Funghi del Suolo, (Paperback)
Save with
Trichoderma Sp. I Biologiczna Kontrola Grzybw Glebowych, (Paperback) $57.00

$5700
current price $57.00Trichoderma Sp. I Biologiczna Kontrola Grzybw Glebowych, (Paperback)
Save with
Related Products
Nomenclature of Plants; a Text for the Application by the Case Method of the International Code of Botanical Nomenclatur, (Paperback)
Nomenclature of Plants; a Text for the Application by the Case Method of the International Code of Botanical Nomenclatur, (Paperback)$19.70current price $19.70The Healing Power of Celtic Plants: Their History, Their Use, and the Scientific Evidence That They Work Men, (Paperback)
The Healing Power of Celtic Plants: Their History, Their Use, and the Scientific Evidence That They Work Men, (Paperback)$25.15current price $25.15
